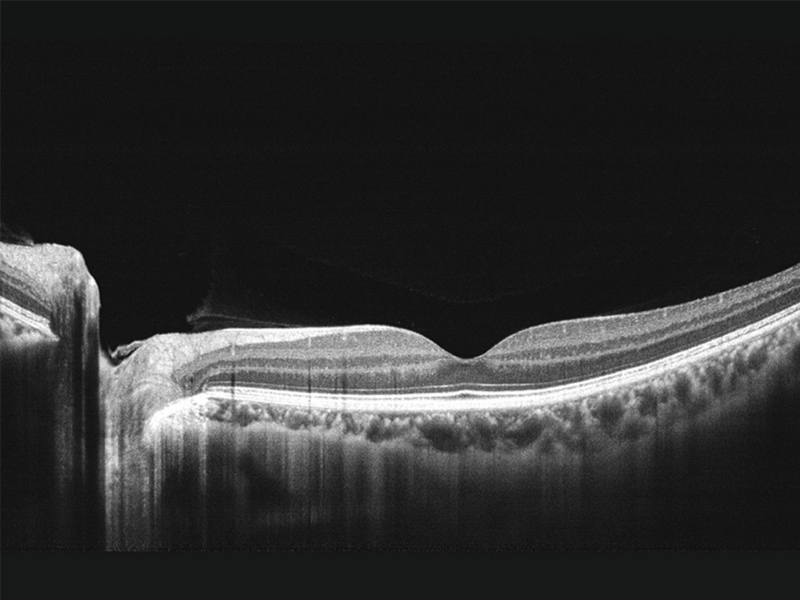
Tomograf in coerenta optica MOCEAN 4000

Tomograf in coerenta optica MOCEAN 4000
Descriere
Tomograful in coerenta optica MOCEAN 4000 utilizeaza tehnologia SD-OCT, avand o viteza de baleiere de 80.000 scan/secunda. Acesta permite scanari de pana la 3.1 mm pentru segmentul posterior si ofera vizualizare angle-to-angle cu 16 mm latime pentru segmentul anterior.
Este necesara achizitionarea suplimentara pentru: monitor, imprimanta, tastatura, mouse.
Cod: P13253
Furnizor:
CERTAINN TECHNOLOGY
Informaţii despre Tomograf in coerenta optica MOCEAN 4000
- Caracteristici
- Specificaţii tehnice
- Examinări
- Set de livrare
- Certificate
- Consumabile
- Opţionale
- Accesorii
- Compatibilitate
- Manuale utilizare
Caracteristici
Tomograful in coerenta optica MOCEAN 4000 prezinta urmatoarele caracteristici:
- imagine OCT de inalta calitate;
- imagini retiniene in timp real la 45° SLO;
- urmarirea retinei in timp real bazata pe SLO reduce in mod eficient artefactele cauzate de miscarea ochilor;
- analiza retinei, glaucomului si corneei.
Specificaţii tehnice
OCT
Metoda
domeniul spectral OCT
Lungime de unda
840 nm
Viteza de scanare
80.000 scan/s
Rezolutie axiala
5 µm (optic)
3.6 µm (digital)
Rezolutie transversala
15 µm (optic)
3 µm (digital)
Dioptrii
-20D la+20D
Imaginea fundului de ochi
Metoda
LSLO (Line-Scanning Laser Ophthalmoscope)
Diametrul minim al pupilei
3 mm
Camp de vizualizare
45°±1°
Specificatii generale
Putere
90 VA
Alimentare
100-240 V, 50-60 Hz
Dimensiuni (Lxlxh)
532x360x540 mm
Greutate
30.5 kg
Set livrare produs
#
Denumire
Buc.
Observaţii
3
Unitate PC
1
4
Protectie obiectiv
1
5
Husa de protectie
1
6
Cablu de alimentare
1
7
Manual de utilizare
1
Accesorii
Mese cu elevatie
-
Masa electrica T100 pentru MOCEAN 3000, 4000
COD PRODUS: P15727Capacitate sustinere: 120 kg
Dimensiuni blat: 1000x570 mm